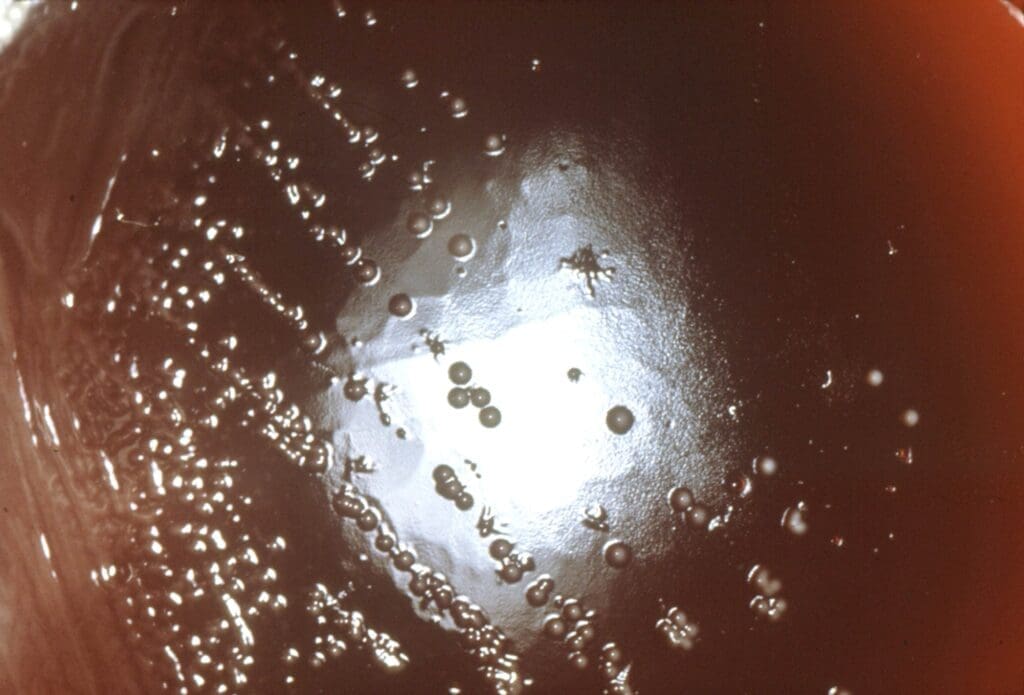

Proteus
Substance Background
The Proteus bowel nosode is prepared from cultures of Proteus species originally isolated by Edward Bach from human intestinal flora and later extensively studied by John Paterson. Proteus is a Gram-negative, highly motile, non-lactose-fermenting organism belonging to the Enterobacteriaceae, closely related to coliforms and frequently implicated in urinary tract and wound infections in conventional microbiology.Paterson’s later bacteriological work showed that the “B. Proteus” nosode in practice represents a small complex of related strains (including Proteus vulgaris, Proteus penneri, Proteus myofaciens and allied organisms), all sharing intense proteolytic activity and a marked capacity to disturb the autonomic and vascular systems. For homeopathic use, Bach prepared the nosode by serial dilution and succussion of sterile filtrates of these cultures, transforming their toxic irritant effects into a deep-acting remedy that primarily reflects “storms” of the nervous system, acute surges of adrenergic activity, and violent vascular reactions.
Proving Information
There is no Hahnemannian proving of Proteus in the strict sense. Its picture arises from Paterson’s “clinical proving” based on thousands of cases with stool cultures showing Proteus predominance, followed by prescription of the nosode and careful observation. He emphasised that mental symptoms were “prominent in the clinical proving” and chose “Brain Storm” as the keynote, indicating sudden, violent nervous upsets with outbursts of temper, hysteria, convulsions and meningeal irritation.Later authors have expanded this picture with clinical experience and repertorial analysis, confirming Proteus’ association with acute mental tension, autonomic overload, hypertension, digestive storms, photosensitivity and sensitivity to meteorological changes. The remedy is thus predominantly [Clinical] and [Toxicological] in origin, with provings “in the field” rather than in controlled provers, but its keynotes have been stable over many decades.
Remedy Essence
The essence of Proteus can be condensed into the phrase: “held tension that breaks in storms.” The patient is a human counterpart of the mythic Proteus—the shapeshifting sea-god associated with the smell of decay and the unpredictability of the sea—and of the organism Proteus, whose foul odours and invasive potential mirror the disturbing quality of the nosode. On the psychological level, Proteus people are those who carry immense loads of stress, anxiety and responsibility while keeping up appearances of control, only to experience periodic explosive discharges when the strain becomes intolerable.
At rest, they may appear serious, introspective, even withdrawn. They are often conscientious, functioning under high expectations, both internal and external. They may be pillars of family or work, absorbing others’ burdens while suppressing their own distress. Yet beneath the surface lies a boiling mixture of anger, fear and exhaustion. When provoked, contradicted or struck by bad news, this latent storm erupts: they lose temper violently, scream, throw things, or collapse into hysterical sobbing, trembling and physical upheaval. Children demonstrate this vividly in Proteus tantrums—lying on the floor, kicking, screaming, resisting all control.
The body faithfully reflects this pattern. Tension localises in the epigastrium; as stress builds, the solar plexus tightens like a knot. Sympatho-adrenal activation follows: pulse races, blood pressure shoots up, hands tremble, sweat breaks out, the face flushes, and the head pounds. The organism seeks release through every possible outlet: vomiting, diarrhoea, urination, rashes, tears, shouting. When the storm passes, there is profound exhaustion and often guilt over the outburst. This pattern recurs with every major stressor, and over time the cardiovascular and digestive systems bear the brunt: chronic hypertension, recurrent “panic attacks” with adrenergic flavour, and functional dyspepsia or colitis punctuate the patient’s life.
Externally, Proteus patients are tuned to storms: barometric changes, thunder, high winds and electric weather all aggravate. They may predict storms by their headaches and nervousness. Internally, they struggle with “storms of the mind”—brain storms, as Paterson called them—where mental instability, explosive anger and hysterical reactions surface despite a strong will to keep control. Thus the remedy sits at an axis between Nux-v. (driven, irritable, overworked) and Ign. (contradictory, hysterical under grief), with additional cardiovascular–hypertensive and neuro-vegetative dimensions that neither covers fully.
Miasmatically, Proteus expresses psora (functional over-reactivity), sycosis (repetitive, recurrent crises, accumulation of tension), and syphilis (destructive potential in vascular crises, suicidal depression, and episodes of mental breakdown). If untreated, the synergy of these miasms under modern lifestyle pressures can lead to serious pathology: hypertensive strokes, cardiac events, ulceration, and psychiatric collapse. Proteus does not cure such conditions alone, but by re-ordering the bowel–nervous–vascular axis, it can reduce the frequency and severity of crises and open the door for deep constitutional remedies.
Clinically, the Proteus essence is often encountered in:
- Executives, carers or professionals under chronic pressure, with episodic hypertensive crises, panic-like episodes, digestive storms and eruptive anger;
- Adolescents under academic and social stress, with dramatic tantrums, self-harm risks, and digestive–nervous storms;
- Adults with longstanding histories of “nerves,” sensitive to storms, <a href="https://www.iqhomeopathy.com/materia-medica/sol/">sunlight and chemicals, whose symptoms move in multi-system surges rather than simple alternations.
Once Proteus is appropriately prescribed, several changes are often seen: storms become less frequent and less violent; blood pressure surges moderate; digestion stabilises; and the patient begins to recognise and express emotion earlier, with less sudden eruption. In that calmer terrain, a more stable constitutional pattern appears—Nat-m. grief, Aur. despair, Sulph. psora, or Lyc. portal congestion—allowing classical prescribing to act with greater predictability. In this sense, Proteus is a deep “organiser” of the stress–gut–nervous network, particularly suited to modern life’s relentless demands.
Affinity
- Central and peripheral nervous system – Proteus has a powerful affinity for the nervous system, especially sudden discharges of nervous energy: “brain storms,” hysterical crises, convulsive tendencies, meningismus and spasm of the peripheral nerves. This is reflected throughout Mind, Head, Back, Extremities and Generalities, where intense nervous tension, tremors, neuralgic pains and shock-like sensations are prominent.
- Autonomic (sympatho-adrenal) system – The remedy acts on the sympathetic nervous system and adrenal axis, with violent surges of adrenaline-type reactions: palpitations, tremor, sweating, diarrhoea, vomiting and rashes during acute stress, excitement or bad news. These features recur in Mind, Heart, Stomach, Abdomen, Skin and Fever and underlie the “all systems discharge at once” pattern.
- Cardiovascular system and blood pressure – Proteus is closely related to hypertensive states, peripheral vasospasm (cold or mottled extremities), vertigo from high blood pressure and headaches aggravated by storms and meteorological changes. Chest, Heart, Head and Generalities sections all echo this cardiovascular affinity.
- Peripheral circulation and vasospasm – Spasm of peripheral vessels, Raynaud-type phenomena, mottled or cyanosed extremities, and abrupt changes of circulation with emotional upsets are well noted for Proteus.This affinity links to Extremities, Chill / Heat / Sweat and Generalities.
- Digestive tract (especially epigastrium) – Proteus patients “feel their tension in the epigastrium”; they tremble, perspire, vomit, get diarrhoea, urinate and break out in rashes from excitement. Stomach, Abdomen, Rectum and Generalities reflect these nervous-digestive storms and sensitivity to food, wine and eggs.
- Skin and photosensitivity – Acute eruptions and rashes triggered by emotional shock, excitement, solar exposure (photosensitivity to ultraviolet light) and irritant chemicals (including chlorine-treated water and beauty parlour treatments) fall under Proteus’ sphere. This affinity appears in Skin, Fever and Generalities.
- Emotional field of extreme tension and control – Proteus acts deeply in people who endure prolonged stress with rigid self-control; when control snaps, they explode in rage, tears, hysteria or violent physical symptoms. This is the core of the Mind picture and underpins Sleep and Dreams as well.
- Weather and atmospheric changes – The nosode is highly sensitive to storms, changes of barometric pressure and atmospheric electricity, which aggravate headaches, hypertension, neuralgic pains and nervous storms. This is woven through Head, Extremities, Generalities and Fever.
- Shock and trauma (especially emotional) – While not a first-line acute shock remedy like Acon., Proteus has a role in the chronic aftermath of severe shock, repeated stress or bad news, especially when these have left the patient in a state of constant inner tension prone to sudden discharges. Mind, Heart, Stomach, Skin and Clinical Tips all reflect this.
- Bowel flora and chronic dysbiosis – As a bowel nosode, Proteus shares with its group a deep influence on chronic intestinal dysbiosis; however, its emphasis is less on food allergy or alternation (as in Mutabile) and more on sharp, nervous-digestive crises linked to stress and adrenergic excess.This appears in Stomach, Abdomen, Generalities and Differential Diagnosis.
Better For
- Better for discharge of emotion (crying, shouting) – When pent-up feelings are expressed, whether by a storm of tears, an angry outburst or even writing and talking, the Proteus patient often feels physical relief: headache, epigastric tension, palpitations and trembling lessen as the emotional pressure is released. This is reflected in Mind, Stomach, Heart and Generalities.
- Better in open air (especially after storms) – Fresh air and exposure to the elements, particularly once a storm has passed, often soothe the sense of inner pressure and clear the head, though strong winds or storms themselves can aggravate beforehand. Head, Respiration and Generalities reflect this.
- Better for gentle warmth and rest in bed – In contrast to some bowel nosodes, Proteus patients often like warmth and feel better wrapped up and resting in bed, recuperating from stress and “nervous weather.” This shows in Mind, Fever, Extremities and Generalities.
- Better for steady routines and reduction of external stress – Symptom storms become less frequent and intense when routines are stable, demands are moderated and the patient is not constantly overstretched; Mind and Generalities emphasise this.
- Better from moderate, regular meals – While digestion is sensitive, small, regular meals of simple food tend to reduce epigastric tension and prevent sudden vomiting or diarrhoea compared with heavy, irregular or provocative eating. Stomach, Abdomen and Food and Drink echo this.
- Better after stool, vomiting or other “release” – The typical Proteus storm (tension → tremor → sweating → vomiting/diarrhoea/urination/rash) often ends in a sense of relief once discharge is complete, reflected in Stomach, Abdomen, Rectum and Skin.
- Better from heat on the stomach and epigastrium – Warm applications or sipping warm drinks can relax the “knot” in the epigastrium and reduce neuro-vegetative symptoms, cross-linking Stomach and Generalities.
- Better for consoling yet respecting need for space – There is ambivalence: they avoid company yet become anxious when left entirely alone. Quiet, non-demanding support nearby can ease tension without feeling intrusive, highlighting Mind and Sleep modalities.
- Better after storms have broken – Many Proteus complaints are worse before and during storms; after the storm passes, both externally and internally, they feel calmer, paralleling Head and Generalities.
Worse For
- Worse from prolonged external stress and overwork – Long periods of strain, responsibility, deadlines or care-giving load up the nervous system; Proteus patients keep functioning with iron self-control until a “brain storm” breaks out in physical or mental form. Mind, Heart, Stomach and Generalities show this clearly.
- Worse from storms, thunder, and changes in barometric pressure – Headaches, hypertension, neuralgic pains and mental instability are all aggravated by approaching storms and sometimes by electrical disturbance in the atmosphere. Head, Generalities, Extremities and Fever all echo this.
- Worse from contradictions, opposition, or thwarted will – Being opposed, contradicted, or blocked in their plans can precipitate sudden violent temper, hysterical scenes or physical crises (tremor, vomiting, diarrhoea). Mind and Generalities highlight this.
- Worse from mental shock or bad news – Sudden grief, frightening news or shocking events trigger storms: palpitations, trembling, sweating, vomiting, diarrhoea and rashes; the whole organism “discharges” under the shock. Mind, Heart, Stomach, Skin and Fever show this.
- Worse from UV <a href="https://www.iqhomeopathy.com/materia-medica/sol/">sunlight and photosensitivity – Proteus patients may be unusually sensitive to <a href="https://www.iqhomeopathy.com/materia-medica/sol/">sunlight and ultraviolet exposure, with headaches, rashes or exhaustion triggered by bright sun. Skin, Head and Generalities reflect this.
- Worse from wine, eggs and rich or stimulating food – Wine and eggs are highlighted as specific aggravators, alongside generally rich or provocative foods, which precipitate digestive and nervous storms. Stomach, Abdomen, Skin and Generalities link to this.
- Worse from chlorine and chemical irritants – Bad effects of skin treatments involving chlorine or harsh chemicals, such as beauty parlour procedures or chlorinated pools, can trigger Proteus complaints. Skin and Generalities carry this keynote.
- Worse from being indoors, tense and constrained – Long hours in confined spaces, under mental pressure and artificial lighting aggravate nervous tension and cardiovascular symptoms, emphasising Mind, Heart and Generalities.
- Worse before menses and under hormonal stress – In women, premenstrual tension intensifies Proteus-like storms: headaches, anger, hysteria, palpitations and digestive crises. This appears under Female, Head and Generalities.
- Worse at night and in the early hours – Many storms occur at night: insomnia, palpitations, diarrhoea, sudden panic, sweating, and brain storms are common at 1–4 a.m., linking Sleep, Heart, Stomach and Generalities.
Symptomatology
Mind
The mind picture of Proteus is dominated by intense inner tension held under tight control until it explodes in a “brain storm”. The keynote phrase given by Paterson—“Brain Storm”—captures the sudden violent upset of the nervous system that may manifest as fits of rage, hysterical outbursts, seizures, or acute mental instability. Such patients can appear controlled, serious and introspective, carrying on with their duties despite ongoing stress; inwardly, however, they feel stretched to the limit, like a tightly wound spring. When opposed or thwarted, they may lose control, throwing objects, kicking, screaming, or having sudden temper fits; children may lie on the floor, kick, and shriek when parental authority blocks their will, a picture closely paralleling some aspects of Nux-v., but with more explosive, nervous-vegetative discharge.
Anxiety in Proteus centres on health and on the consequences of accumulated stress. They are apprehensive about their state of health, often introspective and self-observant, yet ambivalent about company—avoiding it, yet feeling worse when left completely alone. Depression can be profound, coloured by a sense of failure and exhaustion after repeated storms, with suicidal thoughts possible at the nadir, especially when physical complaints (hypertension, palpitations, digestive crises) seem inescapable. Emotional lability is marked: they may cry from anger or frustration, weep from bad news, and yet maintain a facade of control until the snapping point.
Proteus subjects dislike change: they are sensitive to changes of plan, weather, environment or expectations, even though they are themselves subject to internal storms. They may show obsessive tendencies around schedules or safety as a way to control the chaos within. The mental state often includes a mixture of Nux-v.-like irritability and Ign.-like hysteria: intense stress with equally strong emotional control, and when control fails, the result is sudden outburst of symptoms or behaviour. The remedy has been described as “Nux-v. on a bad day” or “the Nux-v. that broke,” emphasising that Nux-v. and Ign. often follow or precede Proteus.
Case [Clinical]: A middle-aged executive, under chronic stress, presented with episodic hypertensive crises, violent headaches before storms, tremors, diarrhoea and vomiting with any bad news, and sudden rages at home. He was self-controlled at work, introspective and anxious about his heart and brain. Proteus 200C, given at long intervals, eased the frequency and violence of storms; subsequently Nux-v. and Ign. addressed residual irritability and grief.
Head
Head symptoms of Proteus are deeply linked to vascular and nervous storms. Violent headaches come suddenly, often with throbbing in temples, occiput and vertex, as if the head would burst, accompanied by flushed face, palpitations and a sense of extreme tension. These headaches are markedly aggravated before and during thunderstorms, sudden changes of barometric pressure, and strong <a href="https://www.iqhomeopathy.com/materia-medica/sol/">sunlight or glare, especially ultraviolet-rich light. Patients may predict storms by their headaches, which carry an “electrical” quality.
Headaches are also triggered by emotional upsets, bad news, anger and mental overstrain, and may be accompanied by trembling, nausea, vomiting, diarrhoea and urination—an all-systems discharge of tension. Relief comes after such discharge, or after crying or rest in a dark, quiet room. The scalp can feel hyperaesthetic, sensitive to combing or touch, and some patients experience electric-shock-like pains through the head or down the spine. In hypertensive subjects, vertigo, buzzing in the head, and sudden blackness before the eyes may accompany the headaches, pointing to the cardiovascular affinity.
Compared with other storm-sensitive remedies (Phos., Gels., Rhod.), Proteus shows far more intense nervous agitation and explosive behaviour during its headaches, and stronger association with bowel and urinary discharge. [Clinical]
Eyes
Proteus has notable ocular features related to photosensitivity and vascular–nervous instability. Patients may be highly sensitive to bright <a href="https://www.iqhomeopathy.com/materia-medica/sol/">sunlight and ultraviolet light; exposure triggers headaches, eye-strain, burning, lachrymation and sometimes rashes or general exhaustion. There may be transient visual disturbances during blood-pressure surges: flashes of light, black spots, blurring, or momentary dimness.
The eyes can feel tense and painful with prolonged concentration under stressful conditions (deadlines, examinations), as if reflecting the tension in the epigastrium and heart. Hyperaemia of conjunctivae, with redness and congestion, may appear during storms or hypertensive episodes, and some patients experience “twitching” of eyelids or periocular muscles when overstretched. Although these symptoms are not as specific as those of Nat-m. or Phos., their occurrence in a Proteus context—storm-sensitive, hypertensive, stress-laden—reinforces the nosode’s choice.
Ears
In the ears, Proteus is marked by sensitivity to noise and possible vascular tinnitus. Loud sounds, sudden noises, and especially thunder may provoke anxiety, palpitations and intensification of headaches. Dull roaring or pulsating noises in the ears may accompany hypertensive surges or vascular storms, improving as blood pressure settles.
Some patients describe transient hearing disturbances during episodes of extreme tension, with muffling or echoing sensation, as if hearing from a distance. Children with Proteus tendencies may be fearful of storms and loud noises, clinging to parents and showing trembling or diarrhoea during thunder. While not an otitis nosode like Morgan Gaertner, Proteus’ ear picture fits its general theme: nervous, vascular reactions to external and internal storms.
Nose
Nasal symptoms are secondary but can mirror vascular and autonomic fluctuations. Congestive coryza may appear before storms, with fullness in nose and frontal sinus and dull frontal headache; as storms break, discharge may increase, then subside. Vasomotor rhinitis with alternating obstruction, especially in nervous individuals, may accompany hypertension and headache phases.
Epistaxis (nosebleeds) can occur during hypertensive surges or emotional outbursts, sometimes bringing temporary relief of head pressure. These episodes tend to be episodic rather than chronic catarrh, differentiating Proteus from more mucous-focused bowel nosodes.
Face
The facial expression in Proteus alternates between strained control and explosive emotion. At rest, the face may appear drawn, lined with care, eyes introspective, mouth tense; during storms it flushes vividly, veins stand out, eyes glare or fill with tears, and the jaw clenches or shouts. The colour can shift rapidly from pallor (during collapse or fear) to congested redness (during rage or hypertensive crises).
Periorbital dark circles may reflect chronic insomnia and mental overstrain. Some patients show a nervous tic, twitching of facial muscles or lips when under tension, again expressing the jittery autonomic terrain. After storms, the face may look exhausted, slack, with a washed-out or ashen pallor.
Mouth
The mouth may show manifestations of nervous and vascular strain: dryness of mouth in anxiety and during storms, a bitter or metallic taste after surges of adrenaline, and occasional aphthous ulcers following periods of extreme stress. Increased salivation can accompany nausea and impending vomiting in digestive storms.
Teeth-grinding (bruxism) may appear in sleep, particularly in overstressed subjects, and there can be tension in the jaw and muscles of mastication during anger; some bite their cheeks or lips unconsciously. These features echo the general theme of tension and discharge without forming a primary keynote.
Teeth
Proteus does not have a strong, unique tooth pathology, but stress-related dental phenomena occur. Grinding of teeth, particularly in sleep or concentration, reflects the muscular and nervous tension; this may lead to dental wear, jaw pain and sensitivity. Toothache may be aggravated by storms or sudden temperature changes and may be associated with vascular congestion.
Children with Proteus tendencies might show increased bruxism during periods of school stress, with improvement during holidays and calm periods, paralleling the mental and general state.
Throat
The throat may constrict during storms: a lump-in-the-throat sensation under emotional stress, spasmodic tightness on bad news or in anxiety, and difficulty swallowing from autonomic spasms. These episodes often accompany palpitations, epigastric tension and urge to vomit or defecate, as part of the Proteus storm.
Recurrent sore throats from strain (shouting in anger, prolonged speaking under tension) may appear, but there is less of the chronic catarrh seen in Morgan or Dysentery Co. nosodes. The sensation of choking or suffocation can occur during panic episodes, overlapping with Ign. and Gels., but Proteus adds the intense epigastric and circulatory dimension.
Stomach
The stomach is a primary theatre of Proteus action. Patients “feel their tension in the epigastrium”: a tight, knotted sensation beneath the sternum, as if the solar plexus were clenched. Emotional stress, bad news, pre-storm weather and confrontation all tighten this knot, which may then release in a cascade of autonomic responses: tremor, sweating, palpitations, nausea and vomiting, diarrhoea and urination. It is as if the organism orders all systems to discharge at once.
The digestion is very sensitive; many Proteus patients are “worse for eating” in general, yet paradoxically “better for it overall” because food (especially moderate, wholesome meals) can ground their tension. Specific aggravations include wine, eggs, heavy or rich foods and perhaps coffee or stimulants; these may trigger epigastric distress and storms. Belching, hiccough, burning or cramping sensations, and sudden vomiting in reaction to emotional or environmental triggers are common.
Case [Clinical]: A woman under chronic family stress had repeated episodes of sudden epigastric knotting with tremors, flushing, palpitations, vomiting and diarrhoea after even minor shocks. She described feeling “all my nerves in my stomach.” Proteus 30C, given cautiously, markedly reduced the frequency and intensity of storms, after which Nat-m. was indicated for her deep grief.
Abdomen
Abdominal manifestations extend the epigastric theme into the intestines. Colicky pains, nervous colitis and acute diarrhoea appear during storms. The patient may feel waves of cramp from epigastrium to lower abdomen, associated with urgent stool and sometimes tenesmus; once the stool is passed, there is often relief of both pain and emotional tension.
Stools can be watery, offensive or mixed with mucus during crises; at other times they are normal, indicating functional rather than fixed pathology. Some experience alternating diarrhoea and normal stools depending on stress levels and weather, differentiating Proteus from more allergy-driven alternations. Gas, distension and borborygmi accompany nervous episodes.
Urinary
Proteus’ urinary picture is linked to its role in conventional urinary infections and to autonomic discharges. Patients may have a history of recurrent cystitis, pyelitis or renal colic, sometimes with foul-smelling urine, though the nosode is chosen more by the mental and nervous features than by local signs alone.During storms, they urinate frequently and urgently, as if the kidneys were being flushed by adrenaline.
In hypertensive patients, transient proteinuria or haematuria may accompany vascular storms and subside as circulation settles. Pelvic and suprapubic spasm can appear with emotional crises, reflecting sympathetic overactivity. Proteus should be considered when urinary troubles appear in a highly stressed, storm-sensitive patient with clear brain-storm and digestive patterns.
Rectum
Rectal symptoms include urgent diarrhoea during emotional shock or storm onset, with feelings of insecurity about control of sphincters. At the height of the storm, tremors and palpitations may force the patient to rush to the toilet with explosive evacuation. After the storm, rectal function returns to baseline.
Occasionally, haemorrhoidal congestion appears during hypertensive surges, with a feeling of fullness and throbbing; bleeding may accompany stool during these episodes and bring some relief of head pressure, reflecting the vascular dimension.
Male
In men, Proteus may manifest in sexual and prostatic spheres during stress. Libido can be erratic, often reduced by chronic strain, but occasionally heightened in manic or stormy phases. Performance anxiety and fear of failure can trigger typical Proteus storms: palpitations, epigastric tension, sweating, diarrhoea, and collapse of desire.
Prostatic congestion during stress, with frequent urging, incomplete emptying and perineal discomfort, may be reported. Erectile difficulties intensify during periods of extreme pressure and improve when emotional tone and blood pressure are stabilised by the remedy and lifestyle changes.
Female
In women, Proteus interacts with hormonal swings. Premenstrual tension can be extreme: irritability, rage, crying from anger, headaches, breast tenderness, hypertensive surges and digestive storms are all heightened in the days before menses. Menses may come suddenly, like the storms themselves, sometimes bringing partial relief.
Some women experience nausea, vomiting and diarrhoea at the onset of bleeding, especially if menses coincide with external stress or storms. Climacteric periods may show hypertensive crises, palpitations, hot flushes and emotional outbursts, calling for Proteus when the bowel nosode background fits.
Respiratory
Respiration is quickened during storms: dyspnoea, hyperventilation, sighing and the sense of “cannot get enough air” are features of panic and adrenaline rush. There may be chest tightness during storms and thunder, yet the lungs are structurally sound.
Some Proteus patients complain of breathlessness during hypertensive surges or epigastric tension episodes, which improves after vomiting, diarrhoea or emotional discharge. True allergic asthma with alternation of skin symptoms belongs more to Mutabile; in Proteus, breathing difficulty is primarily neuro-vegetative.
Heart
The heart is a key organ in Proteus. Palpitations are sudden, violent and frightening, often perceived in the epigastrium as well as the chest. Patients may have episodes of tachycardia with pounding in the head, trembling and sweating, occasioned by storms, stress, anger, exertion or even anticipation. Hypertension is common: blood pressure rises sharply during storms, sometimes with vertigo, visual disturbances and risk of vascular events.
Cardiac pains may be constrictive, radiating, or simply feelings of tightness rather than true ischaemic angina, though Proteus may coexist with structural heart disease in modern patients. The autonomic aspect is crucial: fear of heart attack, fear of dying in the storm, and a tendency to check pulse and blood pressure repeatedly. After a well-indicated dose of Proteus, these paroxysmal cardiovascular episodes tend to reduce in frequency and intensity, making way for constitutional remedies to address remaining pathology.
Chest
In the chest, Proteus expresses both cardiac and respiratory tensions. An oppressive weight on the chest may accompany storms, with a sense of impending catastrophe, as if the heart would fail. Palpitations, irregular beats and rapid pulse are associated with anxiety, storms, or bad news. The chest may feel squeezed by a band, echoing arterial spasm.
Respiratory symptoms are generally secondary: sighing respirations, hyperventilation in panic states, and occasional asthmatic episodes triggered by stress. These do not alternate with skin or bowel symptoms in the Mutabile sense but rather co-occur with global storms.
Back
Back symptoms reflect tension along the spine. Sharp, electric-shock-like pains may shoot from occiput down the spine during storms; stiffness and aching of neck and upper back arise during prolonged desk work and stress. Spinal muscles can spasm with nervous tension, leading to a sensation of a “steel rod” down the back.
During acute storms, there may be trembling along the spine, with shuddering and cold sweat, as if the whole axis were shaking. Some cases of meningismus and convulsive states responding to Proteus suggest irritation of meninges and spinal nerves in feverish illnesses, linking back to Paterson’s description.
Extremities
In the extremities Proteus displays its vascular and nervous affinities. Hands and feet may be cold, mottled, cyanosed or intermittently flushed, depending on vaso-motor tone. Spasms of peripheral circulation produce transient numbness, tingling or burning sensations in fingers and toes, sometimes aggravated before storms or under emotional stress.
Trembling of hands and legs is common during storms, especially when epigastric tension is high; the patient may drop objects or find handwriting shaky. Cramps in calves, feet or hands may accompany adrenergic episodes. In chronically hypertensive patients, claudication, heaviness and weakness of limbs under exertion may be present, though these require careful differentiation and medical management alongside homeopathy.
Skin
The skin in Proteus reflects acute discharges of tension and reactions to environmental irritants. Rashes may erupt suddenly under emotional shock, excitement or storms, often as erythematous patches, urticaria or blotches. Photosensitivity is notable: exposure to <a href="https://www.iqhomeopathy.com/materia-medica/sol/">sunlight or UV lamps provokes erythema, burning, itching or more systemic collapse. Chlorine-treated water and harsh cosmetic or beauty parlour treatments can trigger rashes and aggravations, for which Proteus is especially recommended.
Eruptions may be accompanied by sweating and shaking, and frequently appear alongside digestive and cardiovascular symptoms during storms. Unlike Morgan-pure or Mutabile, chronic eczemas are less the hallmark; instead, acute neuro-vegetative rashes and flushes form the skin signature, though chronic photosensitive or chemically triggered dermatoses may also respond.
Sleep
Sleep in Proteus patients is often restless, light and easily broken by internal or external storms. They may lie awake for hours, mind racing with worries about health, family, work or impending disasters. When they do sleep, it is unrefreshing; they wake tired, with residual epigastric tension or headache. Night-time is a classic time for storms: palpitations, sweats, diarrhoea and panic attacks often wake them between 1 and 4 a.m.
Falling asleep can be difficult after evening stress or stormy weather; some feel an anticipatory dread as night approaches, fearing heart attack or stroke. Others crash into heavy sleep after an episode of brain storm and discharge, then wake feeling as if they had been beaten. In children, nightmares of storms, monsters or being chased may cause sudden waking with screaming and trembling.
Dreams
Dreams often reflect the themes of tension, control and catastrophe. Patients dream of storms, floods, earthquakes and other forces of nature out of control; of fighting, arguing and losing self-control; of being chased, cornered, or unable to escape danger.
Health-related themes may appear: hospitals, operations, heart attacks, sudden death, or collapse in public. Dreams can be vivid, dramatic and leave the patient anxious on waking, with epigastric tightness or palpitations. Occasionally dreams provide an outlet: in dreams they may shout, fight or cry freely, whereas in waking life they hold back, reinforcing Proteus’ polarity between control and discharge.
Fever
In feverish conditions Proteus may show meningismus, convulsions and nervous storms, especially in children. Paterson observed that convulsive and epileptiform seizures in children during febrile attacks often respond to Proteus, particularly when accompanied by intense irritability, kicking, screaming and refusal of control.Fever may be high, with flushed face, hot head, cold extremities and profuse sweating accompanying digestive and urinary discharges.
However, Proteus is more a chronic terrain remedy than an acute pyretic remedy; its fever picture is significant when embedded in the broader history of storm-like episodes, stress, hypertension and neuro-vegetative crises.
Chill / Heat / Sweat
Thermal regulation is unstable. Chills may alternate with flushes of heat in rapid succession, especially under emotional strain or barometric shifts. Chills often start in the spine or extremities and may be accompanied by gooseflesh; heat rises to head and chest, bringing flushing, throbbing and sweating.
Sweats are often profuse during storms, particularly cold clammy sweats on face, palms and epigastrium when the patient feels faint or overwhelmed. Night sweats may occur in chronically stressed, hypertensive subjects, soaking bedclothes and leaving them exhausted. Ill-timed sweats (profuse at the least effort) reflect autonomic dysregulation.
Food & Drinks
Food relationships are distinctive. Many Proteus patients notice aggravation from wine and eggs, triggering headaches, digestive storms or rashes. Rich, heavy, spicy and stimulating foods may also provoke episodes, particularly in the evening or under stress. Yet there is a paradox: overall, they feel “better for eating,” as moderate food intake stabilises blood sugar and anchors the nervous system.
During acute storms, nausea, vomiting and diarrhoea prevent eating; afterwards, they crave simple, warm, bland food. Some resort to alcohol (including neat whisky) as a form of self-medication to blunt tension, a modality sometimes cited as amelioration by neat whisky—dangerous in the long term but characteristic of the Proteus emotional terrain.
Generalities
Generalities in Proteus revolve around the polarity of control versus storm. These patients live on the edge of their nervous system’s capacity, holding an immense load of responsibility, grief, fear or pressure under a facade of control. Over time, this unrelieved tension expresses itself in paroxysmal crises: brain storms; explosive anger; hysterical outbreaks; hypertensive surges; acute digestive discharges; and rashes.
They are sensitive to storms and barometric changes—worse before and during thunderstorms, better afterwards; sensitive to bright light (especially UV), chemical irritants (chlorine, strong scents, beauty parlour agents), and environmental noise. The autonomic signature is striking: tremors, sweats, palpitations, diarrhoea, vomiting, urination and rashes can all appear in a single crisis. Physical strength may be adequate or even high between episodes; fatigue follows storms, with a need for bed-rest and recuperation.
Miasmatically, Proteus stands at the intersection of psora (functional hypersensitivity), syphilis (destructive impulses, suicidal risk, vascular crises) and sycosis (periodic, recurrent surges, tendency to hypertrophy and congestion). It is especially useful in modern life where chronic stress, environmental assaults and suppression of emotional expression generate a pattern of “wired and tired” individuals: high tension, high performance, sudden crashes.
Proteus is less about alternating organ systems (as in Mutabile) and more about multi-system storms driven by the nervous and vascular axes. When you see a case of Nux-v.-Ign.-Nat-m.-Acon. mixture, marked by stress, anger, self-control, sudden explosions and adrenergic crises, Proteus may be the hidden bowel layer maintaining the pattern. When correctly prescribed, it often reduces the intensity and frequency of storms, enabling more classical constitutional remedies to act clearly.
Differential Diagnosis
Aetiology & Terrain (bowel nosodes)
- Proteus vs Mutabile – Both are bowel nosodes, but Mutabile shows changeability and alternation (skin ↔ asthma ↔ kidneys ↔ bowel), with Pulsatilla softness and atopy. Proteus shows extreme tension and “brain storms,” hypertension and sudden crises, less multi-organ alternation and more global discharge. Mutabile suits the atopic child; Proteus the overstressed adult or adolescent.
- Proteus vs Morgan-pure – Morgan-pure is more congestive, portal, skin and liver-focused with Sulphur-like traits; Proteus is nervous–vascular with Nux-v.–Ign. traits. Morgan-pure deals with chronic congestive states; Proteus with acute nervous storms on a dysbiotic terrain.
- Proteus vs Gaertner – Gaertner’s core is malnutrition, assimilation failure and underweight children with poor immunity. Proteus may appear in more robust yet overstressed individuals with hypertensive and nervous crises rather than pure malnutrition.
- Proteus vs Bacillus No. 7 – Bacillus No. 7 suits degenerative musculo-skeletal and ageing conditions. Proteus suits younger to middle-aged patients under stress, with dynamic nervous and circulatory storms.
Mind & Emotional Field
- Nux-v. – Both are irritable, overworked, overstimulated. Nux-v. is more driven, ambitious, angry at interruptions but generally retains control; Proteus reflects the Nux-v. milieu when control fails and eruptions of hysteria, storms and multi-system discharges occur. After Proteus, Nux-v. may cover the remaining pattern.
- Ign. – Ign. covers hysterical grief, contradictions and internalised suffering with periodic outbursts. Proteus overlaps but is more adrenergic, stormy and linked to hypertension and digestive storms. Ign. may follow Proteus when grief becomes central after storms diminish.
- Nat-m. – Nat-m. internalises grief and resentment, showing migraines, silent suffering and aversion to consolation. Proteus may precede Nat-m. in those who have moved from stormy, Proteus-like reactions into deeper inward depression. Nat-m. has less overt adrenergic storm and more crystallised sorrow.
- Aur. – Aur. shares suicidal tendencies and vascular risk (hypertension), but Aur. is more serious, duty-bound, morally rigid, with bone and periosteal pains. Proteus is more stormy, hysterical and digestive, with bowel-nosode background.
Cardio–Vascular & Nervous
- Acon. – Acon. is the acute remedy for sudden terror and tachycardia after fright; Proteus suits the chronic terrain of repeated shocks and storms leading to recurrent crises. Acon. handles the immediate reaction; Proteus the underlying predisposition.
- Glon. – Glon. has intense pulsating headaches and vascular surges, especially from heat and sun; Proteus adds the nervous storms, digestive discharges and bowel nosode context. Glon. is acute; Proteus chronic.
- Gels. – Gels. has anticipatory anxiety, trembling, weakness, and drooping; Proteus has more explosive anger and storms, and greater hypertensive emphasis.
Digestive & Stress
- Nux-v. – Already noted; a close relative. Nux-v. predominates in digestive toxicity and irritability from sedentary lifestyle and stimulants; Proteus in neuro-vegetative storms with multi-system discharge and greater storm/weather sensitivity.
- Arg-n. – Arg-n. has gastric anxiety, diarrhoea from anticipation and fear of failure. Proteus overlaps in stomach-centred tension and diarrhoea from excitement but adds the hypertensive, storm-sensitive, bowel-nosode layer.
Skin & Chemical Sensitivity
- Sulph. – Sulph. is hot, itching, philosophical, often slovenly, with chronic skin eruptions aggravated by heat and washing. Proteus has more acute, stormy eruptions, photosensitivity, and chemical (chlorine) reactions, with less constitutional psoric burning.
- Rhus-t. – Rhus-t. has vesicular eruptions and sensitivity to weather, but is more musculo-skeletal and less nervously stormy. Proteus suits cases where chemical exposure and emotional storms drive rashes.
Remedy Relationships
- Complementary: Nux-v. – Nux-v. and Proteus are intimately related; Proteus has been described as “Nux-v. on a bad day,” and Nux-v. often follows Proteus when acute storms subside and typical Nux-v. functional pathology remains.
- Complementary: Ign. – Ign. complements Proteus in patients with deep grief and emotional contradictions. Proteus clears adrenergic storms; Ign. then addresses core grief and inner conflict.
- Complementary: Nat-m. – Nat-m. may follow Proteus when long-standing grief and reserve emerge after storms lessen; Nat-m. brings deeper reorganisation of emotional life and migraine patterns.
- Complementary: Kali-phos. – For exhausted nervous systems after repeated storms, Kali-phos. rebuilds nerve tone while Proteus reduces the propensity to storms.
- Follows well: Acon. – After Acon. has dealt with immediate shock, Proteus may help those whose system remains hyper-reactive, storm-sensitive and prone to repeated crises.
- Follows well: Mutabile – In atopic patients who move from changeable skin–lung alternations (Mutabile) into more overt nervous and hypertensive storms, Proteus may be the next bowel nosode layer.
- Precedes well: Aur., Nat-m., Sulph., Lyc. – Proteus clears the storm layer, after which clear constitutional images often emerge; Aur. for severe depression with cardiovascular risk, Nat-m. for deep grief, Sulph. and Lyc. for psoric and portal aspects.
- Related nosodes: Morgan-pure, Bacillus No. 7, Dysentery Co. – These form part of the complex interplay of bowel nosodes; Proteus is chosen when brain storms, storms of nature, hypertension and adrenergic crises dominate.
Clinical Tips
- Use Proteus when chronic stress plus bowel nosode indications have created a pattern of recurrent “storms”: sudden headaches, hypertension, palpitations, epigastric knots, vomiting, diarrhoea, tremors and rashes, especially during storms or after bad news. A single dose of 30C or 200C, repeated only when clearly indicated, can markedly reduce the intensity of crises.
- In patients resembling Nux-v. or Ign. but with stronger cardiovascular and digestive storms, think of Proteus as an intercurrent bowel nosode. After Proteus, Nux-v. or Ign. may act more cleanly on the remaining functional disturbances.
- For hypertensive patients with marked weather sensitivity, barometric headaches, and digestive–nervous storms, Proteus may be indicated alongside strict orthodox monitoring and lifestyle measures. It is not a substitute for antihypertensives but may reduce paroxysms and associated anxiety.
- For skin reactions after chlorine exposure or beauty parlour treatments, especially in storm-sensitive, stressed individuals, consider Proteus when other skin remedies fail to address the underlying nervous and chemical sensitivity.
Case pearl [Clinical]: A 42-year-old teacher with long-standing hypertension had violent headaches before storms, flushes, pounding heart, epigastric cramps, vomiting and diarrhoea after confrontations at school. She feared brain haemorrhage and had become addicted to sedatives. Proteus 200C, single dose, led to markedly fewer storms; blood pressure spikes reduced and she could be managed with lower doses of conventional medication. Nat-m. later addressed her grief over a lost child.
Case pearl [Clinical]: An adolescent boy, described as “Nux-v. gone wild,” had explosive temper, threw objects when contradicted, complained of stomach knots before exams, and had bouts of diarrhoea and vomiting with trembling and sweats. He feared thunder and storms and had recurrent headaches with weather changes. Proteus 30C, given once monthly for three months, transformed his reactivity; afterwards, Nux-v. and Kali-phos. helped stabilise his studying and sleep.
Case pearl [Clinical]: A cosmetician developed acute rashes, headaches, palpitations and diarrhoea after exposure to chlorinated water and hair-bleaching agents at work, accompanied by extreme stress and storm phobia. Conventional allergy regimens brought little relief. Proteus 30C reduced the intensity of rashes and systemic storms; Phos. and Rhus-t. later handled residual photosensitivity and joint pains.
Selected Repertory Rubrics
Mind
- Mind; storm; internal “brain storm” – Sudden violent nervous and mental upsets with explosive behaviour.
- Mind; anger; violent; throws things – Outbursts of rage with throwing, kicking, striking when opposed.
- Mind; anxiety; health; about; with hypertension – Fear of serious disease during storms and surges.
- Mind; hysteria; grief; from bad news – Hysterical reactions to shock and bad news with crying, tremors, digestive storms.
- Mind; control; loss of; after long strain – Sudden breakdown after prolonged self-control and stress.
- Mind; suicidal; despair; after repeated storms – Depression with suicidal thoughts following recurrent crises.
Head
- Head; pain; storms; before; during – Headaches aggravated by approaching or ongoing thunderstorms.
- Head; pain; sun; from; with photosensitivity – Headaches from bright <a href="https://www.iqhomeopathy.com/materia-medica/sol/">sunlight or UV exposure.
- Head; congestion; hypertension; with – Head feels as if it would burst in blood-pressure surges.
- Head; pain; epigastrium; tension; with – Headache with knot in stomach and nervous storms.
- Head; pain; vomiting; after; better – Relief of headache after vomiting during crises.
Chest / Heart / Respiration
- Chest; oppression; anxiety; with palpitations – Tight chest with fear and palpitations in storms.
- Heart; palpitations; storms; during – Violent palpitations aggravated by thunderstorms and barometric changes.
- Heart; hypertension; paroxysmal – Sudden rises of blood pressure with headaches and fear.
- Respiration; dyspnoea; anxiety; from – Shortness of breath in anxiety storms, with hyperventilation.
Digestive (Stomach / Abdomen / Rectum)
- Stomach; tension; epigastrium; from emotional stress – Knot at solar plexus during worry or anger.
- Stomach; vomiting; excitement; from – Vomiting from joy, bad news, fright or exam stress.
- Abdomen; diarrhoea; excitement; from – Loose stools from anticipation, fear, or storms.
- Abdomen; colic; storms; during – Cramping abdominal pains during thunderstorms.
- Rectum; stool; sudden; urgent – Sudden urgent diarrhoea during crises.
Skin
- Skin; eruptions; emotional causes; from – Rashes triggered by emotional outbursts or stress.
- Skin; eruptions; chlorine; from – Dermatoses after exposure to chlorinated water or chemical treatments.
- Skin; photosensitivity; <a href="https://www.iqhomeopathy.com/materia-medica/sol/">sunlight; from – Skin reactions and headaches from UV exposure.
- Skin; urticaria; excitement; from – Hives arising during emotional storms.
Generalities
- Generalities; storms; before; aggravates – Symptoms worse before and during thunderstorms.
- Generalities; stress; prolonged; effects of – Chronic effects of long-term stress, leading to recurrent crises.
- Generalities; barometric pressure; changes; aggravates – Symptoms sensitive to changes in barometric pressure.
- Generalities; food; wine; aggravates – Wine aggravates digestive and nervous storms.
- Generalities; food; eggs; aggravates – Eggs provoke digestive and systemic reactions.
- Generalities; sun; aggravates – Complaints from sun and UV exposure.
- Generalities; chlorine; aggravates – Aggravations from chlorinated water or chemicals.
References
Paterson, J. — The Bowel Nosodes (1950/1998): primary clinical proving data and keynote “Brain Storm” description of Proteus; mental and nervous-system focus.
Paterson, J. — “The Bowel Nosodes” (Homoeopathic Recorder, 1950): detailed clinical notes on Proteus (Bach) including temper outbursts, convulsions, meningismus and peripheral vasospasm.
Bach, E. — The Role of the Bowel Flora in Chronic Disease (1949): early investigations of non-lactose-fermenting bowel flora, including Proteus, in chronic illness.
Kennedy, C. O. — “The Bowel Nosodes” (Br. Homoeopath. J., 1986): review of Paterson’s work, emphasising remedy–organism–syndrome relationships.
Sharma, C. P., Ambwani, M., Saraswat, K. — “Bowel nosodes – a boon to homoeopathy” (2022): miasmatic classification of bowel nosodes; Proteus placed in psoric and sycotic groups.
Tripathy, T. et al. — “Bowel Nosodes of Homoeopathy in Colorectal Cancer & Other Conditions” (2023): discusses Proteus for bad effects of skin treated with chlorine and broader clinical roles.
Mendonça, V. — “The Therapeutic Role of Bowel Nosodes in Light of Gut Microbiota Research” (2021): modern perspective on composition and systemic influence of bowel nosodes, including Proteus.
WholeHeal — “Notes on Bowel Nosodes – Proteus” (undated): practical clinical summary of Proteus mental picture (brain storm, tension, hysteria), modalities and relationships (Nux-v., Ign.).
Homeopathy texts (various authors) — “The Homeopathic Bowel Nosodes” and related articles: clinical descriptions of Proteus’ mental and physical symptomatology, especially epigastric tension, multi-system discharge and storm sensitivity.
Remedia & related materia medica notes — “Bowel Nosodes – Proteus” (summaries): rubrics and topical notes on vertigo from high blood pressure, mental anxiety about health and nervous–circulatory affinities.
Disclaimer
Educational use only. This page does not provide medical advice or diagnosis. If you have urgent symptoms or a medical emergency, seek professional medical care immediately.